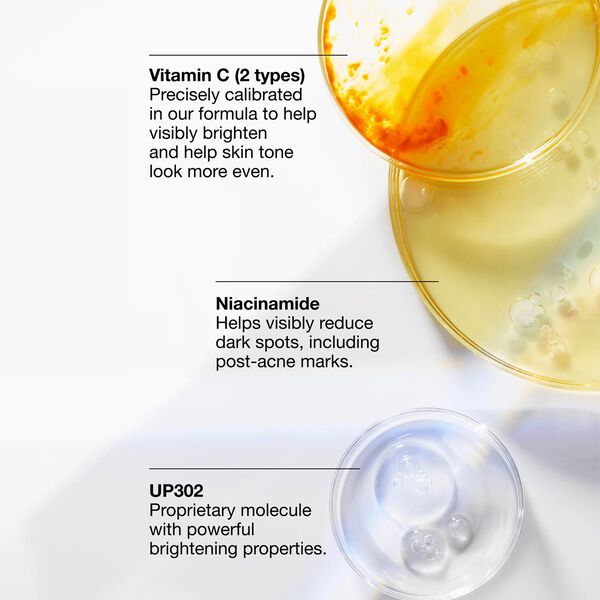

Clinique
Even Better Dark Spot Clearing Serum 30ml
920 kr.
Optjen 920 stjernepoint med
Magasin Goodie
Magasin Goodie
accessibility.variation.selection
Farve:
No color
Størrelse:
50.00 ml
Vælg størrelse
Fri fragt på ordrer over 499 kr. for Goodie medlemmer. Læs mere
30 dages retur. Læs mere
Levering inden for 1-2 hverdage. Læs mere
Hent i forretning. Læs mere
Fordele:
Fugtgivende
Antioxidant
Behandler urenheder
Lysnende effekt
Udjævner hudtonen
Glød & udstråling
Behandler hyperpigmentering
Det gør produktet:
Serummet bekæmper svære mørke pletter og reducerer synligt genstridige pletter, herunder solpletter, alderspletter og mærker efter urenheder. Det hjælper med at forebygge mod fremtidige mørke pletter, mens det beroliger huden. Huden vil fremstå lysere og mere strålende med en jævn hudtone.
Ingredienser:
UP302: Cliniques patenterede lysnende molekyle, der har kraftige antioxidante og lysnende egenskaber.
C-vitamin: Dette serum er lavet med to typer C-vitamin - magnesiumascorbylfosfat og ascorbylglukosid - i en præcist kalibreret formulering. Sammen hjælper disse potente, lysnende antioxidanter med synligt at reducere mørke pletter, herunder mærker efter urenheder, og får hudtonen til at se mere ensartet ud.
Niacinamid: Hjælper med synligt at reducere misfarvninger som mørke pletter og mærker efter akne.
Salicylsyre: Eksfolierer mildt det øverste hudlag for at afsløre en friskere og mere ensartet hud.
Glucosamin: Fremmer eksfoliering af misfarvninger på hudoverfladen og giver en lysere og mere ensartet hud.
Glycyrrhetinic Acid udvundet af lakridsekstrakt: En beroligende ingrediens, der hjælper med at reducere hudirritation, der kan udløse mørke pletter.
Gyokuro: Denne grønne te er håndhøstet i Japan på en sådan måde, at dens naturlige anti-irriterende egenskaber er optimeret til fuldt potentiale. Hjælper med at dæmpe irritation, der kan føre til misfarvning.
Det er klinisk bevist, at serummet synligt reducerer svære mørke pletter på forskellige hudtoner:
- 96% viser synlig reduktion af sol- og alderspletter på lysere hudtoner.*
- 100% viser synlig reduktion af intensiteten af mærker efter pletter på dybere hudtoner.**
Dermatologisk testet. Sikker for sensitiv hud. Testet på alle hudtoner. Allergitestet. 100 % parfumefri.
*Klinisk testet på 55 kvinder efter 8 uger.
**Klinisk testet på 34 kvinder efter 8 uger. Sådan bruger du den:
Brug serummet mod mørke pletter to gange om dagen, morgen og aften.
- Fordel 1 til 2 pump på fingerspidserne.
- Fordel serummet i hele ansigtet, og undgå øjenområdet.
- Følg op med fugtighedscreme.
- Brug solcreme dagligt, når du bruger setummet. Påfør den om morgenen efter din fugtighedscreme.
Anbefalet til dig
GUIDES
Alt det bedste fra skønhedsuniverset
Udforsk vores guides, og bliv inspireret til alt fra at finde den bedste foundation til at vælge din nye yndlingsparfume og pleje din hud bedst muligt.
Vil du se mere Clinique?
Populære skønhedskategorier
- Makeup
- Hårfarve
- Neglelak
- Aloe Vera
- Mascara
- Rejsestørrelser
- Fodpleje
- Ansigtscreme
- Selvbruner
- Eyeliner
- Hår
- Kropspleje
- Solpleje
- Læber
- Fugtpleje
- Ansigtspleje
- Øjenpleje
- Parfumer og dufte
- Ansigtsmasker
- Anti-age
- Hårfjerning
- Deodoranter
- Læbestift
- Lipgloss
- Hygiejne
- Håndpleje
- Shampoo
- Salicylic Acid
- Retinol
- Barbering og hårfjerning
Populære skønhedsmærker
- Ole Henriksen
- The Body Shop
- Rituals
- Bioeffect
- Rudolph Care
- Clinique
- MAC
- Karmameju
- Lancôme
- Kiehl's
- Dermalogica
- Nilens Jord
- Yves Saint Laurent
- Moroccanoil
- Meraki
- The Ordinary
- Revitalash
- Tromborg
- Origins
- Jimmy Choo
- Ecooking
- aesop
- Biotherm
- Elizabeth Arden
- Zarko
- Bodyologist
- Jean Paul Gaultier
- BOSS
- Armani
- Huda Beauty